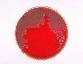

MaeztroUno


KunWari LAng KunWari LAng
sawakas nahanap ko na rin sa tagal ng nakatago..yan...ft..rUstY B..Nd LonElY nG OSD.. At C LAzzy Ng RapAdikz..At uNg bALiw nA Si ocin..

DeliKAdO DeliKAdO
lAstiMano new member namin...check niyo kung gaano sya kalupet... ayyyt,.,,


BAtAs iLokaNo-FuLL VersioN BAtAs iLokaNo-FuLL VersioN
Ft.OcinTenSyAdoR Ng LocoZ LatULo hahaha Boy AN-An!!!


PAgsuboK(.!.) PAgsuboK(.!.)
Kinwento Ni bAliw Ang nArAnAsaN nyA sA PagkAbAliw....Ng Dahil SA DruGS Si OciN NA ReHAB!!!

UrAy PAy nu Cnu K===>iLokAno UrAy PAy nu Cnu K===>iLokAno
PaRA DAw yAn SA biAtCH nI OciN NA Si 'bOO' Na dUmAAn sA PalAd Ko ... hekhek!!!


PAtAwAd MahAl(T_T) PAtAwAd MahAl(T_T)
wala lang poh!!!trip by trip.... la magawa eh!!

SHOOOO!!!!!!!!!!! SHOOOO!!!!!!!!!!!
RepReSentiNg Ng PAgKAbAliw Ni Ocin...HhHAH tunggAin BA NAmN IsAng loNg NEck..HaHAhA
handa ka na ba handa ka na ba
1st. verse....T-KASS....2nd...verse....LiL stiLo.... 3rd...verse...Prin-C-Z-2...chorus..t-kass (recorded@be brown music recordz)

KulAng NA KulANg BA KulAng NA KulANg BA
1st:verse-T-KASS,,,,2Nd:VerSe-MAzTAh FloW 3rd:VerSe-TKASS,,,,, (RECORDED@BE BROWN MUSIC WRECORDZ)

NoTice Me NoTice Me
FirSt:verse-T-KASS,,,SeConD:VerSe-TooLAtE ThiRD:VerSE-DhAw-G.... (RECORDED@BE BROWN MUSIC WRECORDZ)


di ko kaya di ko kaya
1st.verse-dhaw-g,,,lowkey....2nd.verse-t-kass,,,Big-K...3rd.verse-t-kass,,crey-z-g,,t-kass,,,dhaw-g.....chorus by:CrEy-Z-G..... (RecOrDed@L.A.W WReKorDzzz)

Tatlong baguhan Tatlong baguhan
T-Kass,,Ocin ang taong kurad,,PazLhit Chorus CoLLaboration w/ R2K&RBK

kwatros bagitos kwatros bagitos
t-kass,LiL-Strike&LiL-Spike...Ft..OciN Ang AsAwA ni MAdAm NA bAklA...hahaha

